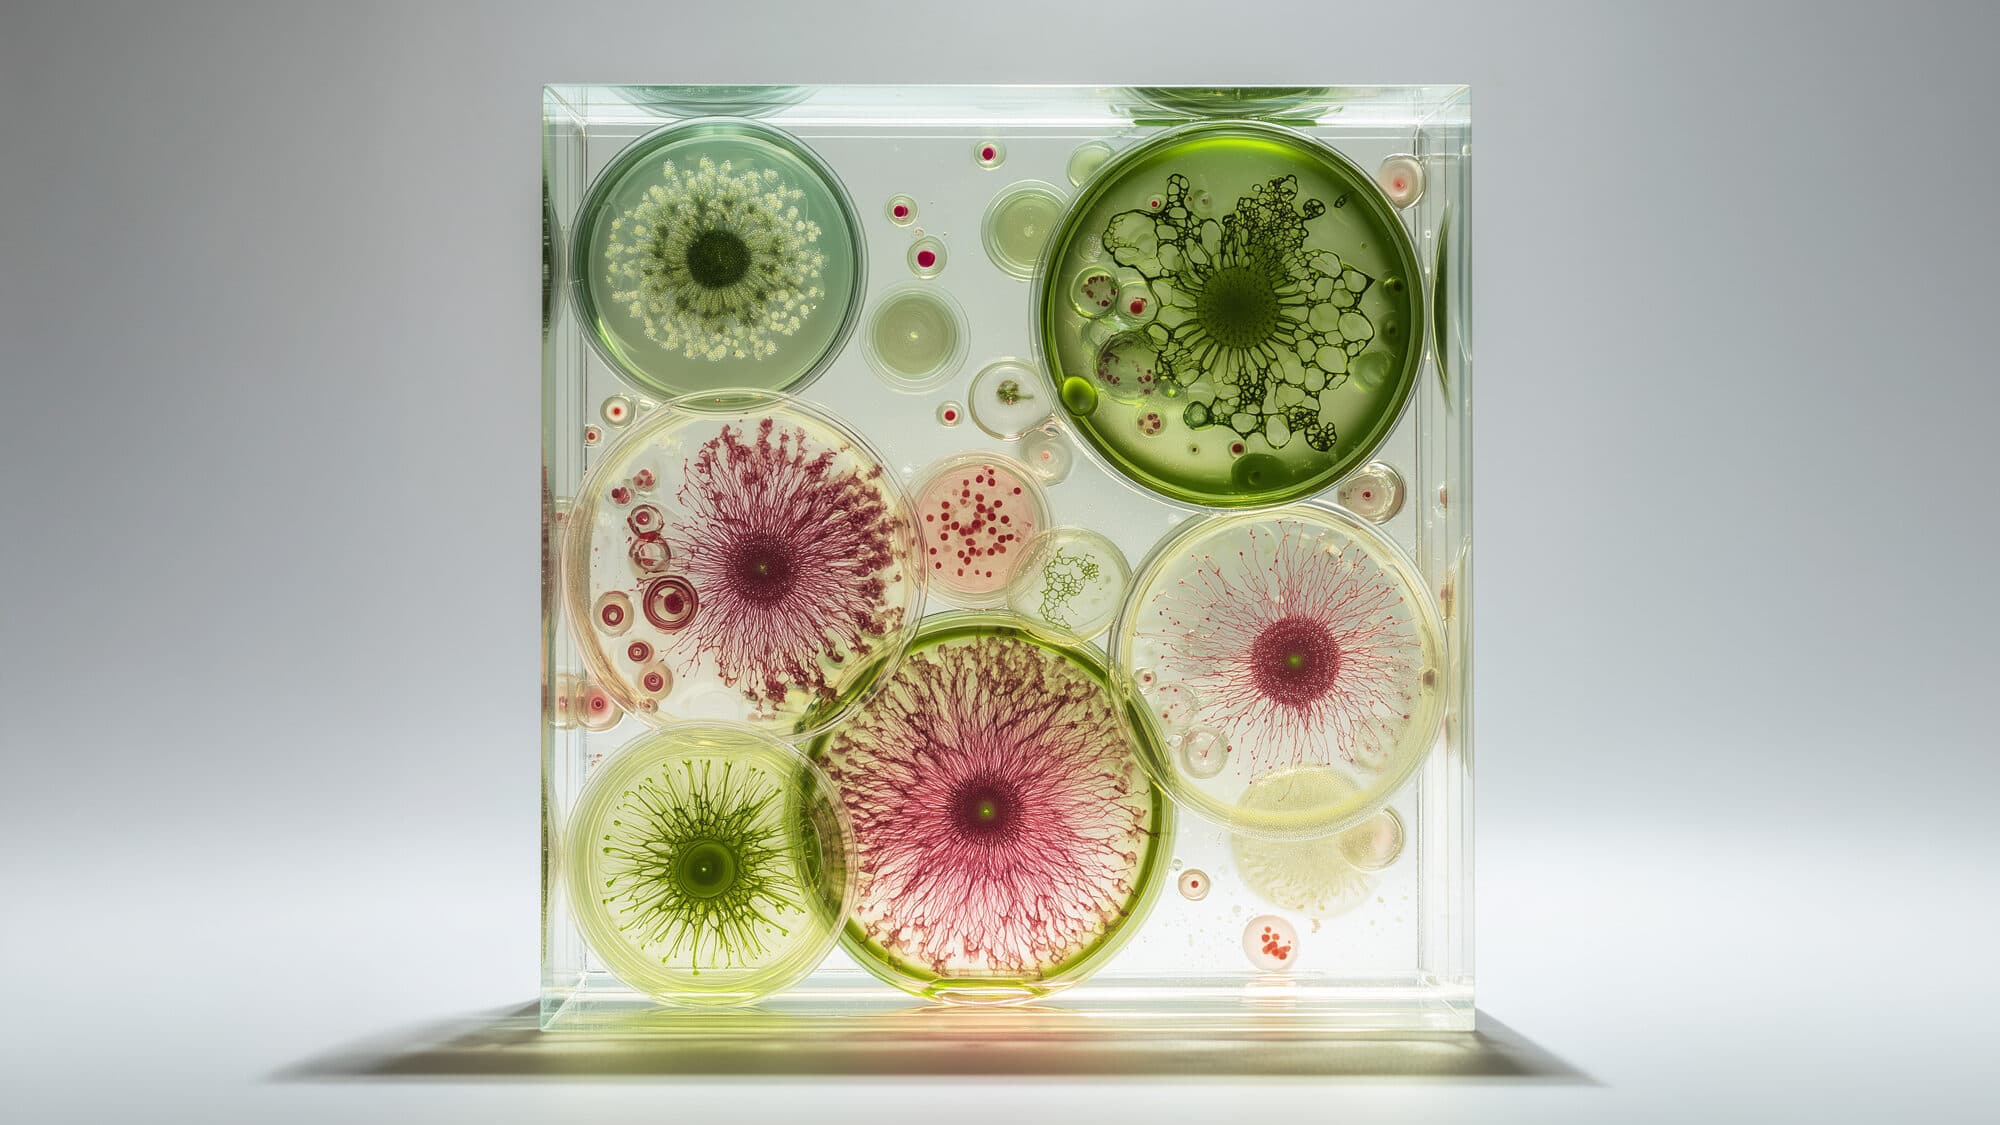
Foto eines Blocks mit farbigen Gewebezellen

Stoffwechsel anregen – welche Rolle spielt das Mikrobiom?
Das Mikrobiom im Darm trägt maßgeblich dazu bei, Nährstoffe, die wir über die Nahrung zu uns nehmen, aufzuspalten und zu verwerten. Wie schnell und gut diese Umwandlung funktioniert ist sehr individuell, genauso wie unsere Zusammensetzung der Darmbakterien.
Ein funktionierender Stoffwechsel ist entscheidend für unsere metabolische Gesundheit, denn wenn hier Störungen vorliegen, kann es langfristig zu einem erhöhten Risiko kommen an Diabetes oder Adipositas zu erkranken. Die Ankurbelung des Fett- und Zuckerstoffwechsels ist dabei ein essentieller Baustein.
Was bewirkt unser Stoffwechsel und warum ist er so wichtig?
Der Stoffwechsel, auch Metabolismus genannt, umfasst alle biochemischen Prozesse im Körper, durch die Nährstoffe aus der Nahrung in Energie und Bausteine für Zellen umgewandelt werden. Er ist essenziell für Gesundheit, Energiehaushalt und Zellregeneration. Ein reibungslos funktionierender Stoffwechsel sorgt dafür, dass Körperfunktionen optimal ablaufen.
Dabei spielt das Mikrobiom im Darm eine zentrale Rolle. Die Mikroorganismen wirken wie ein Steuerzentrum für den Stoffwechsel und beeinflussen unter anderem:
- die Nährstoffaufnahme
- die Regulierung von Blutzucker und Körperfett
- entzündungshemmende Prozesse
- den Schutz der Darmbarriere
Ist die mikrobielle Balance gestört (Dysbiose), kann der Stoffwechsel aus dem Takt geraten: Die Nährstoffverwertung verschlechtert sich, Entzündungen nehmen zu und das Risiko für chronische Erkrankungen steigt. Deshalb ist ein gesundes Mikrobiom der Schlüssel für einen aktiven, gut funktionierenden Stoffwechsel.
Mikrobiom und Stoffwechsel
Der Darm ist nicht nur für die Verdauung zuständig – er ist das Zentrum unseres Immunsystems und Hormonhaushalts. Ein gesundes Mikrobiom im Darm kann den Stoffwechsel beschleunigen und:
- die Insulinsensitivität verbessern
- vor „Leaky Gut“ (durchlässigem Darm) schützen
- systemische Entzündungen reduzieren
- den Fettstoffwechsel regulieren
Ein gestörtes Mikrobiom kann hingegen die Entstehung von Stoffwechselstörungen wie Adipositas, Insulinresistenz und Typ-2-Diabetes fördern. Damit wirkt das Mikrobiom nicht nur lokal, sondern beeinflusst den gesamten Körper.
Aktuelle Forschung & spannende Fakten
Studien zeigen:
- Menschen mit vielfältigem Mikrobiom haben ein geringeres Risiko für Stoffwechselstörungen
- Bestimmte Bakterien-Typen fördern die Produktion kurzkettiger Fettsäuren (z. B. Butyrat), die entzündungshemmend wirken
- Eine gestörte Mikrobiom-Zusammensetzung steht im Zusammenhang mit Insulinresistenz und Übergewicht
- Probiotische Interventionen können den Zuckerstoffwechsel verbessern und den Stoffwechsel anregen
Die personalisierte Mikrobiom-Analyse kann Aufschluss auf den aktuellen Status geben und damit der Startpunkt für individuelle Gesundheitsprävention sein.
Den Stoffwechsel anregen – 5 Wege dein Mikrobiom für einen gesunden Stoffwechsel zu stärken
Health Standard Solutions – Unser Ansatz
Wir entwickeln Mikrobiom-Tests, die Ihren individuellen Status sichtbar machen, und kombinieren diese mit wissenschaftlich fundierten Formulierungen. Ziel ist es, das Mikrobiom gezielt zu begleiten und Impulse für Energie, Balance und Resilienz zu setzen.

Fazit – Ihre Zukunft beginnt im Mikrobiom
Das Darmmikrobiom ist weit mehr als ein Verdauungshelfer. Es ist ein zentrales Organ der Stoffwechselregulation. Seine Bedeutung für Prävention und Therapie metabolischer Erkrankungen wird durch neue Forschung immer klarer.
Wer heute sein Mikrobiom gezielt stärkt, kann aktiv den Stoffwechsel anregen, Stoffwechselstörungen vorbeugen und seine Gesundheit langfristig verbessern.